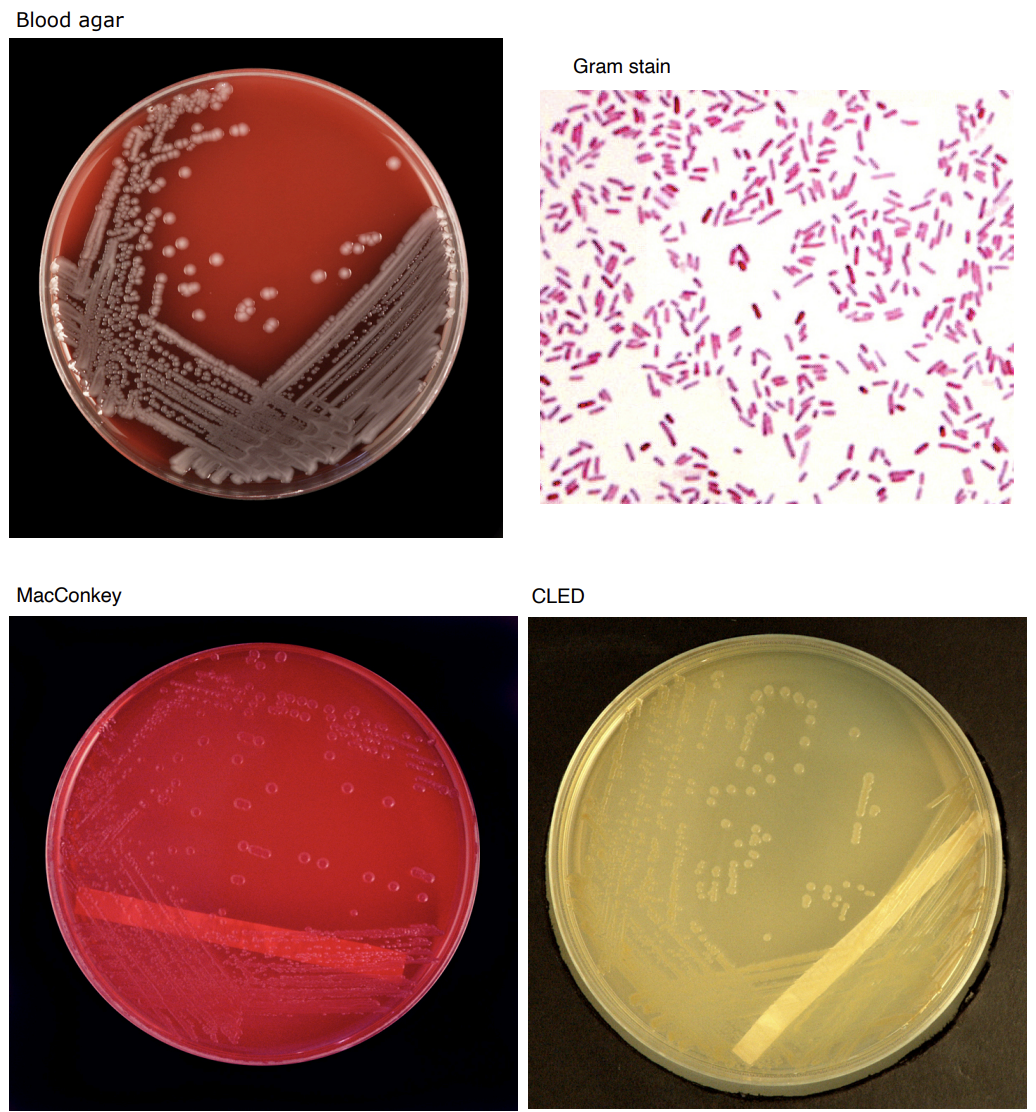
knowt flashcard image
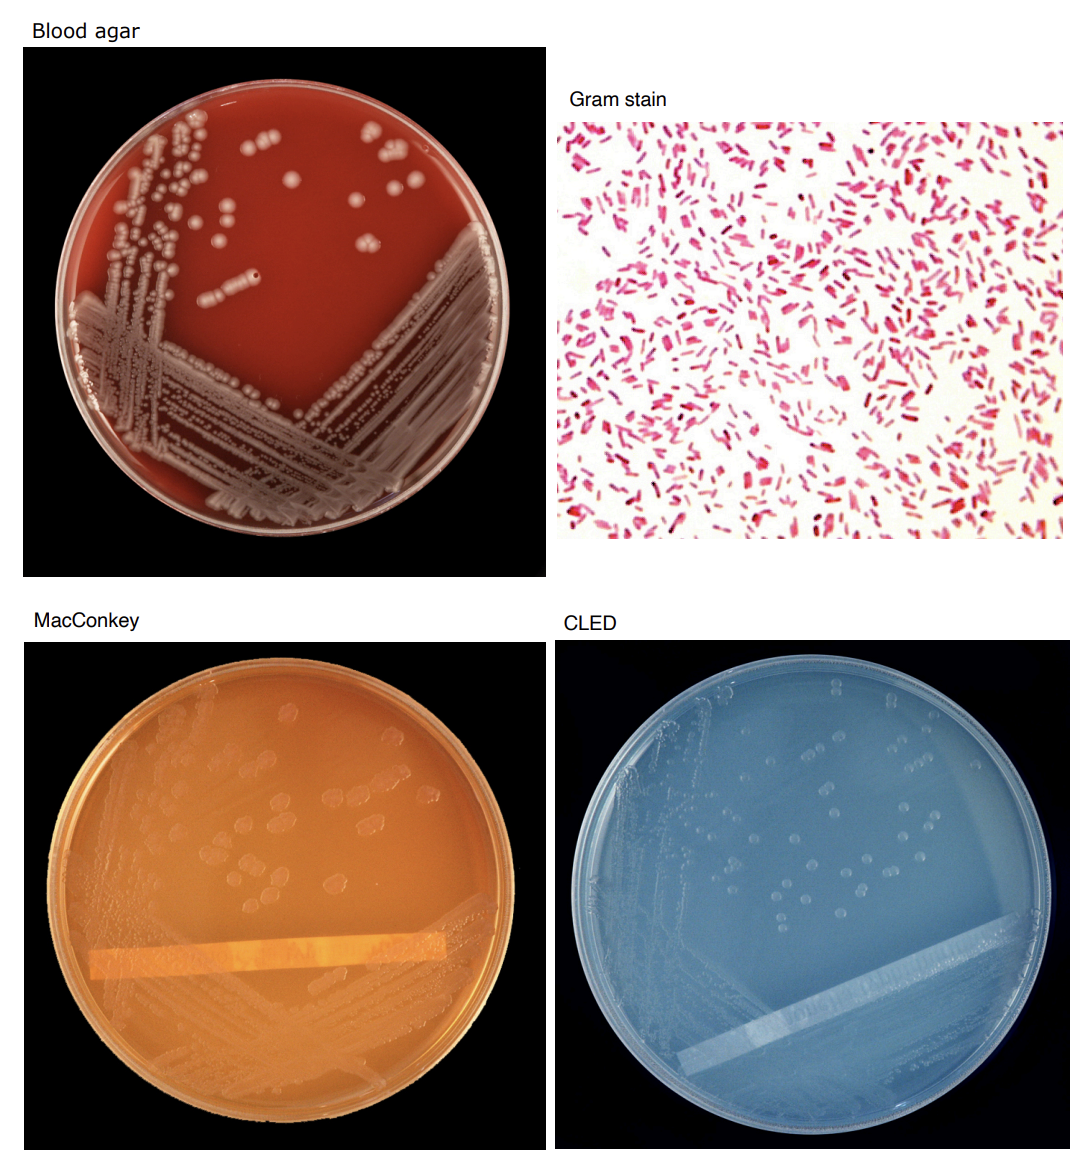
<p>Salmonella</p>
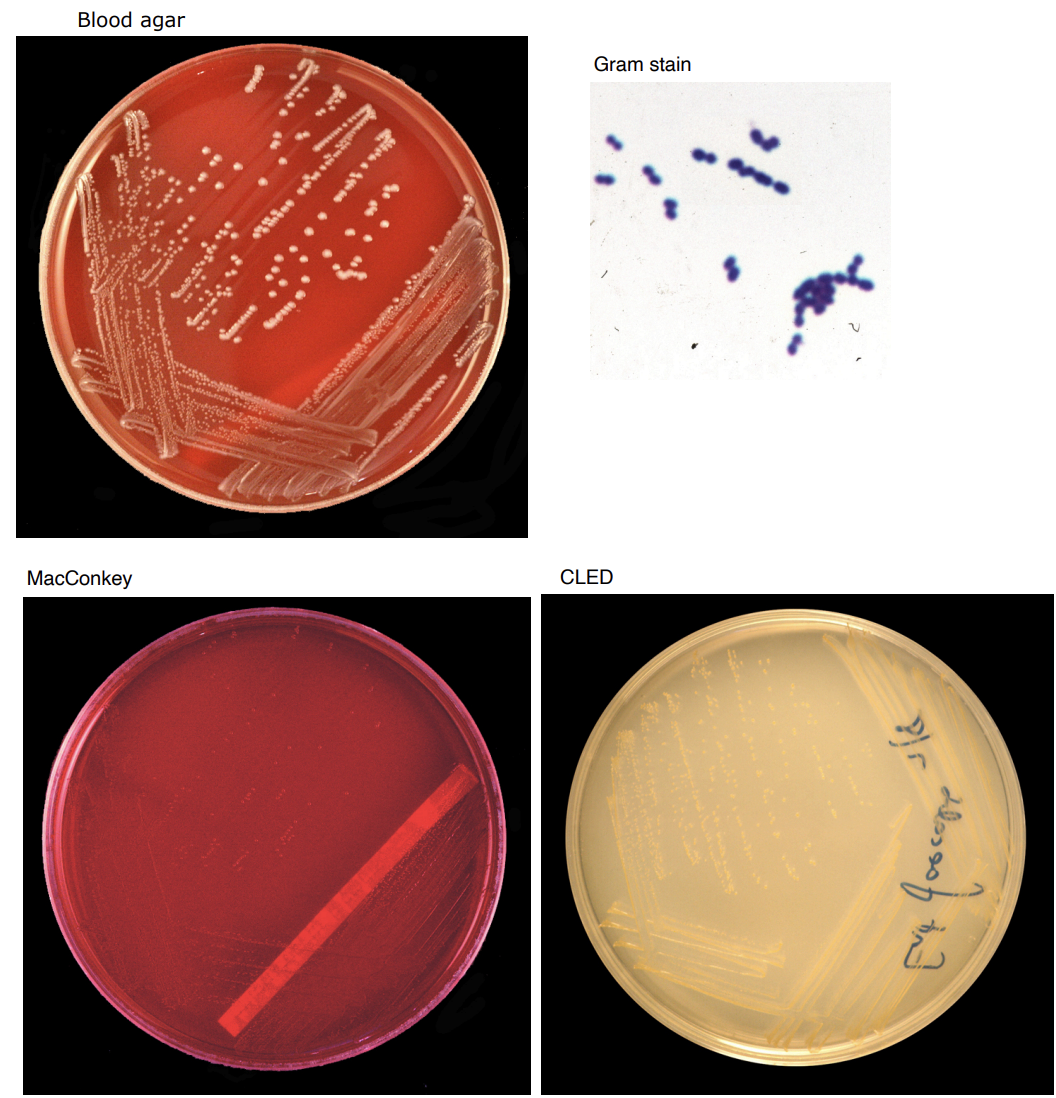
knowt flashcard image
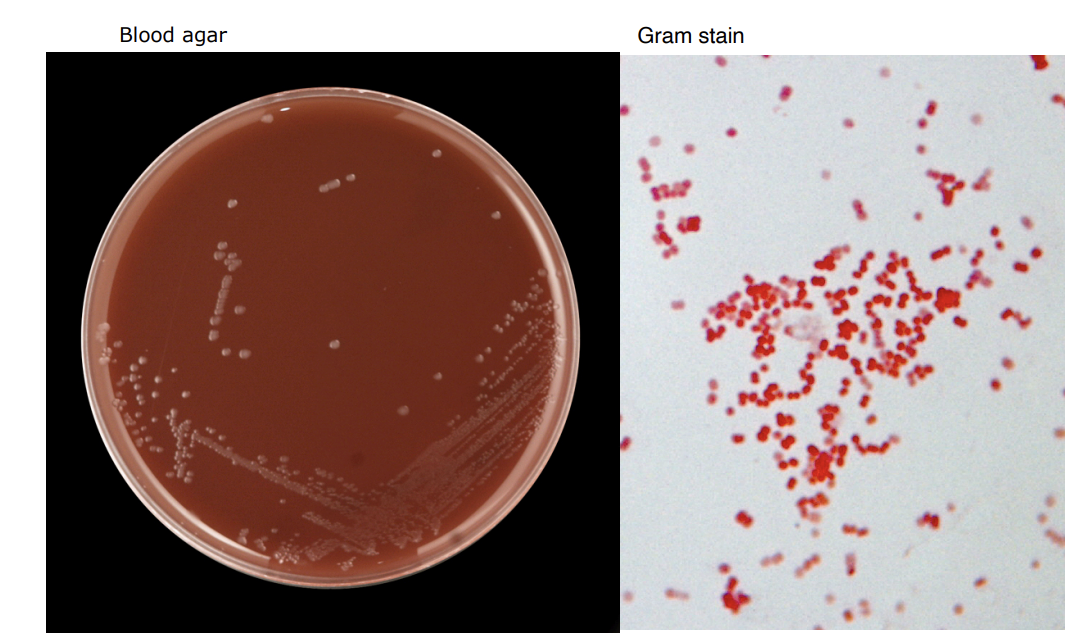
knowt flashcard image
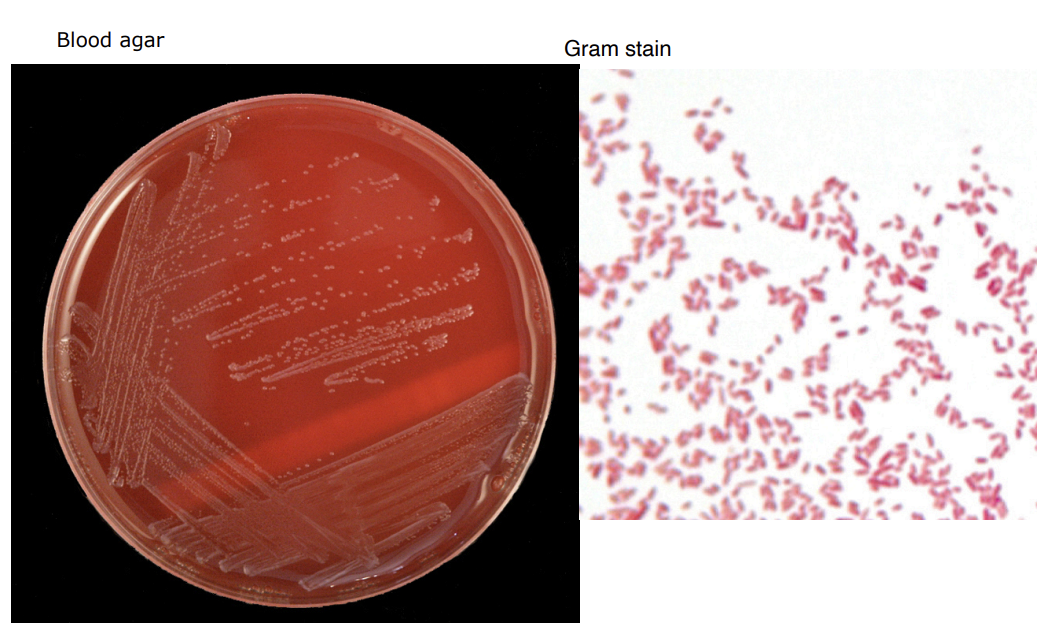
knowt flashcard image
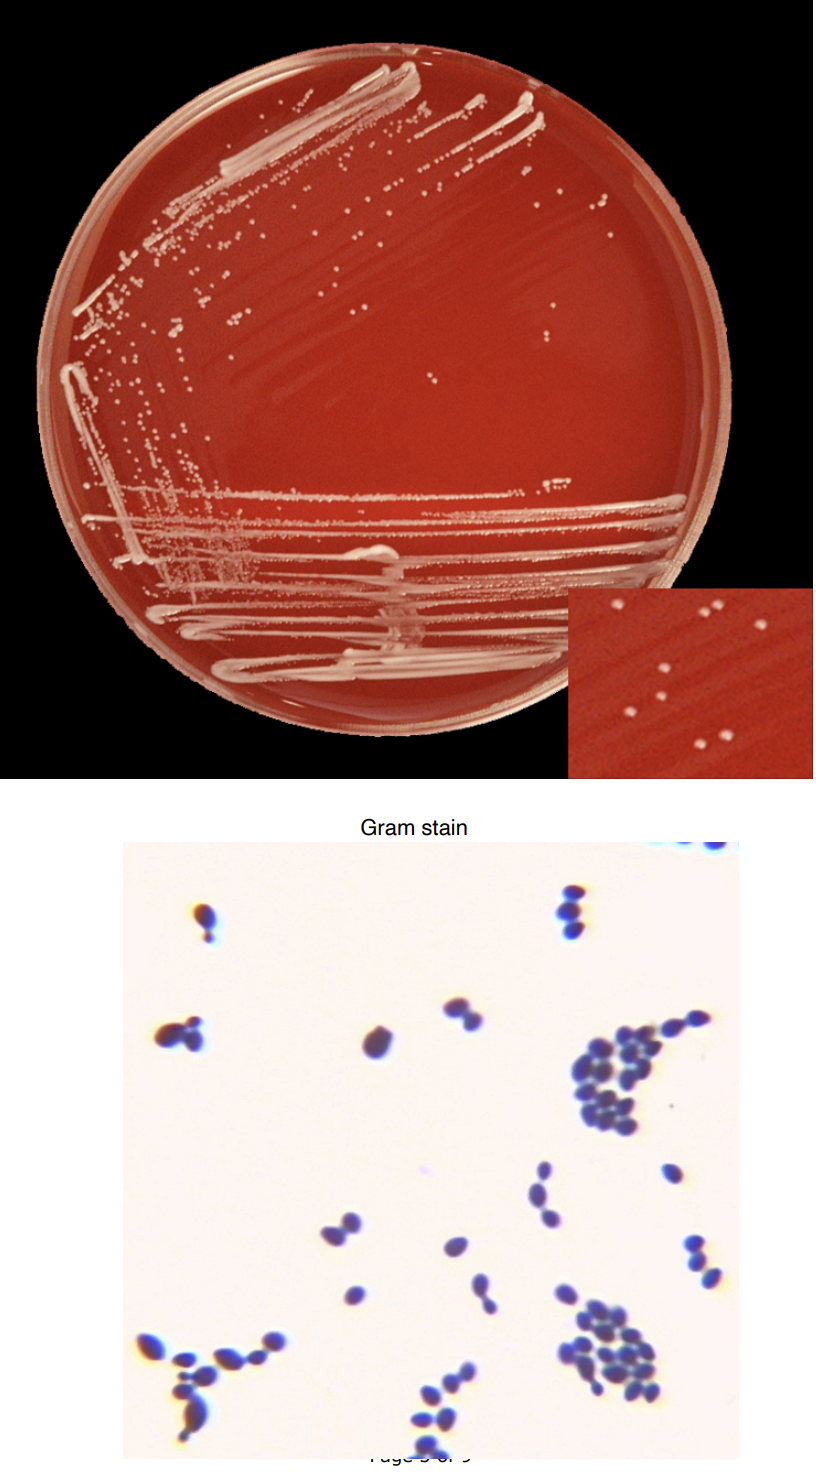
<p>Candida albicans</p>
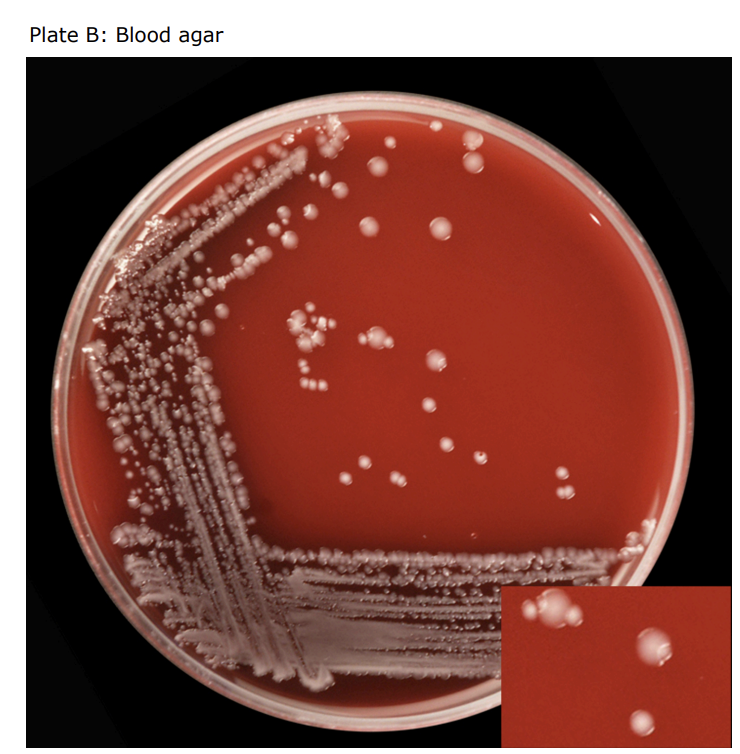
<p>USE OF INDICATOR MEDIUM: CULTURE FROM A FAECAL SWAB</p>
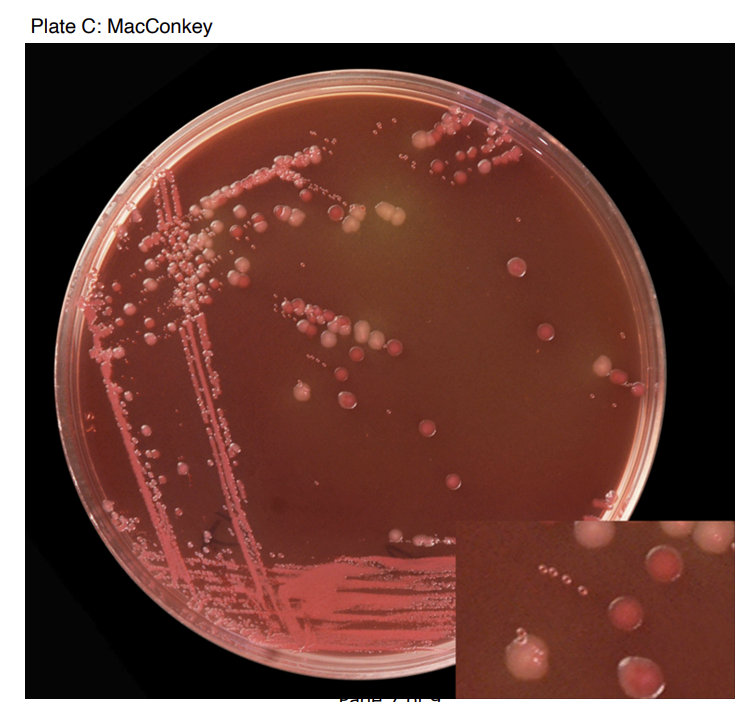
<p>PLATE C: </p><p>Salmonella </p><p>E.coli </p><p>Ent. faecalis </p><p>The MacConkey indicator medium reveals that the larger colonies previously observed on the blood agar are in fact a mixture – large colonies which turn red on the indicator are E.coli and those that remain yellow/white are Salmonella. Consistent with the identification of Ent faecalis, the smaller colonies also turn red on the indicator plate, due to pH reaction.</p>
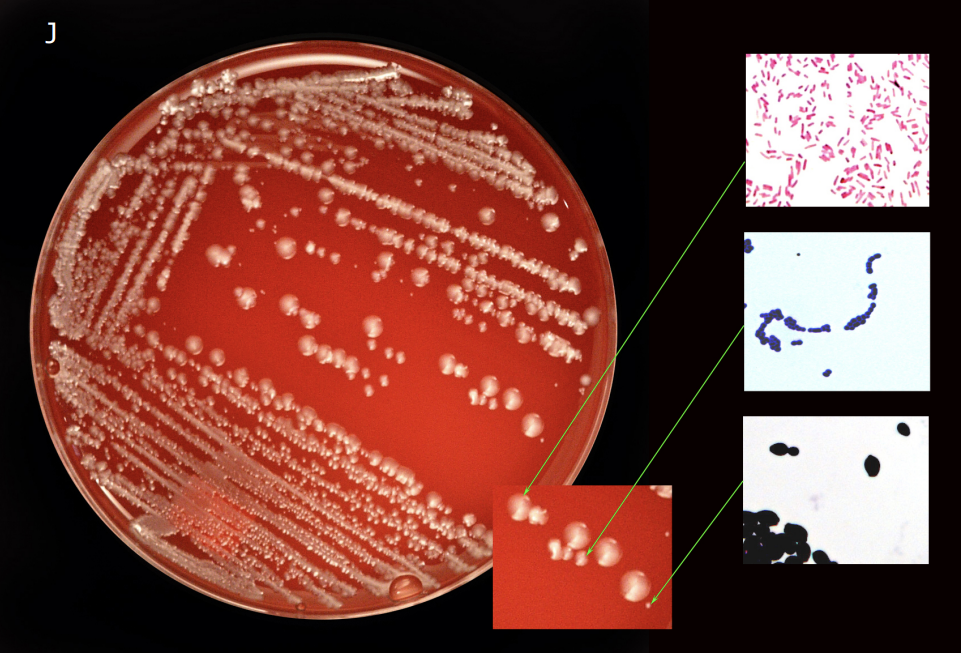
<p>PLATE J: </p><p>Candida albicans </p><p>E. coli </p><p>Ent. faecalis </p><p>There are three colonies present. One large cream colony, a Gram-negative bacillus, which could be either E.coli or Salmonella (considering the source, likely to be E.coli). A medium colony with watery edges, a Gram-positive coccus, that may show chain formation suggesting Ent faecalis. The small colony is small and chalky white and when the organisms are Gram stained appear as large ovoid Gram-positive yeast, which may show some evidence of budding, so is probably Candida albicans.</p>
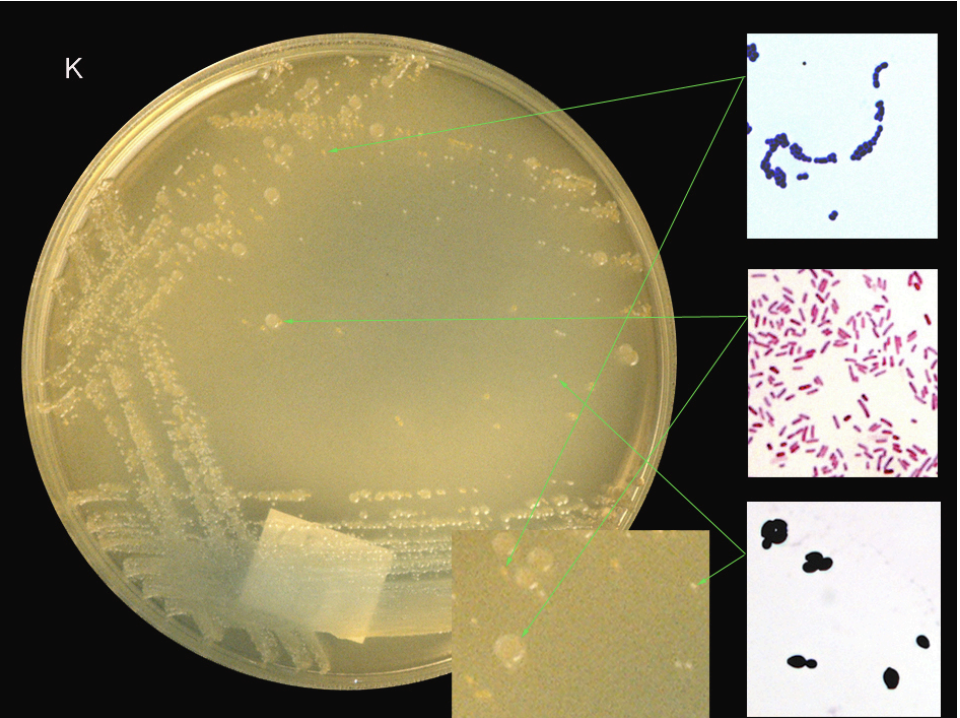
<p>IDENTIFICATION OF ORGANISMS ISOLATED FROM A PATIENT WITH A URINARY TRACT INFECTION</p>
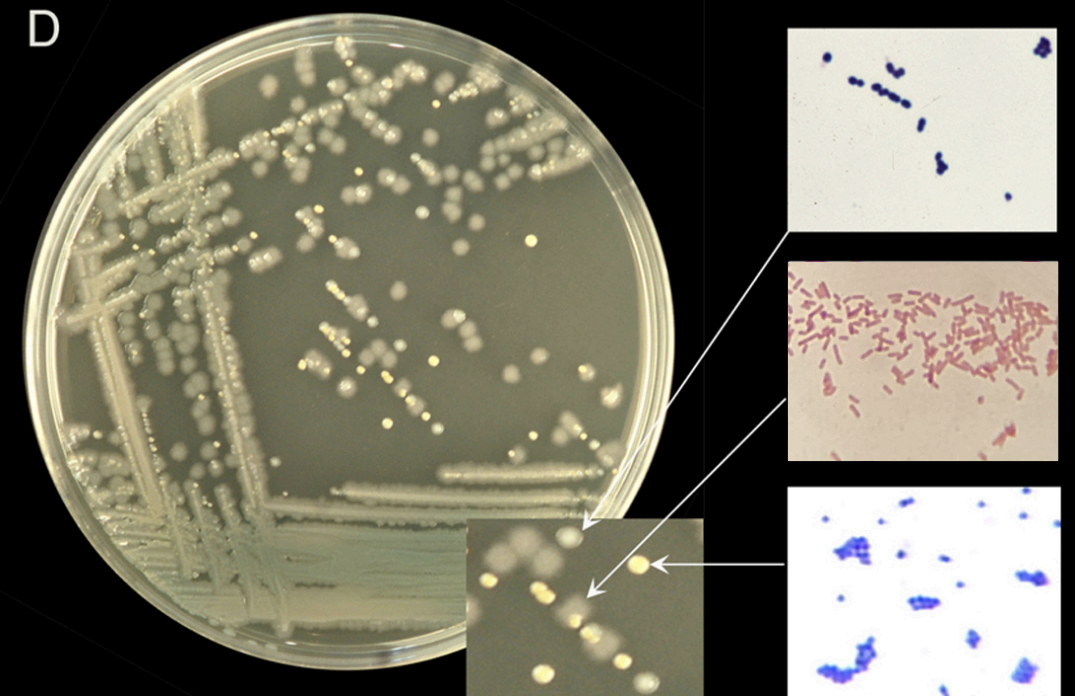
<p>PLATE D: </p><p>Ent. faecalis </p><p>Pseudomonas aeruginosa </p><p>S. aureus </p><p>There are three colonies present. The large amorphous colony producing green pigment is a Gram-negative bacillus, P. aeruginosa. The golden circular colony is a Gram-positive coccus in grape-like clusters, S.aureus. The semi-translucent colony with watery edges is a Grampositive coccus which may show chain formation and is therefore Ent. faecalis.</p>

Practical 18: Pathogenic and commensal bacteria of the gastrointestinal and genitourinary tracts
1/13
There's no tags or description
Looks like no tags are added yet.
Name | Mastery | Learn | Test | Matching | Spaced | Call with Kai |
|---|
No analytics yet
Send a link to your students to track their progress
14 Terms

E.coli

Salmonella


Enterococcus faecalis

Neisseria gonorrhoeae

Bacteroides fragilis

Candida albicans

SEROLOGICAL IDENTIFICATION OF SALMONELLAE


URETHRAL SMEAR FROM A PATIENT WITH GONORRHOEA
A purulent urethral discharge stained by Gram's method. The slide shows a large number of Gramnegative diplococci present in a few of the pus cells (polymorph neutrophil leukocytes). A similar appearance is seen in cerebrospinal fluid smears in meningococcal meningitis.

USE OF INDICATOR MEDIUM: CULTURE FROM A FAECAL SWAB
PLATE B:
Salmonella / E.coli
Ent. faecalis
Blood agar plate shows colonies with two distinct morphologies, large white-ish colonies with watery, diffuse edges and similar smaller white colonies. None of the colonies exhibit any haemolysis. Given the origin of the swab, it is possible that the larger colonies are either Salmonella or E.coli that cannot be distinguished on this medium and the smaller with watery edges are likely to be Enterococcus faecalis, a prevalent commensal. No Gram stains are provided but were this the case it would be predicted that the larger colonies are Gramnegative bacilli, whereas the smaller would be Gram-positive cocci. Thus, using this culture alone it would not be possible to distinguish definitively whether two or more different bacterial species are present.


USE OF INDICATOR MEDIUM: CULTURE FROM A FAECAL SWAB
PLATE C:
Salmonella
E.coli
Ent. faecalis
The MacConkey indicator medium reveals that the larger colonies previously observed on the blood agar are in fact a mixture – large colonies which turn red on the indicator are E.coli and those that remain yellow/white are Salmonella. Consistent with the identification of Ent faecalis, the smaller colonies also turn red on the indicator plate, due to pH reaction.

IDENTIFICATION OF ORGANISMS ISOLATED FROM A PATIENT WITH A URINARY TRACT INFECTION
PLATE J:
Candida albicans
E. coli
Ent. faecalis
There are three colonies present. One large cream colony, a Gram-negative bacillus, which could be either E.coli or Salmonella (considering the source, likely to be E.coli). A medium colony with watery edges, a Gram-positive coccus, that may show chain formation suggesting Ent faecalis. The small colony is small and chalky white and when the organisms are Gram stained appear as large ovoid Gram-positive yeast, which may show some evidence of budding, so is probably Candida albicans.

IDENTIFICATION OF ORGANISMS ISOLATED FROM A PATIENT WITH A URINARY TRACT INFECTION
PLATE K:
Candida albicans
E. coli
Ent. faecalis
Three colonies are present. On CLED, E.coli is confirmed by the creamy-yellow pH reaction, Ent faecalis is confirmed as bright yellow, the third matt-white colony is C.albicans which does not ferment lactose and so does not cause a pH change.


IDENTIFICATION OF ORGANISMS ISOLATED FROM AN INFECTED BURN IN THE INGUINAL (GROIN) REGION
PLATE D:
Ent. faecalis
Pseudomonas aeruginosa
S. aureus
There are three colonies present. The large amorphous colony producing green pigment is a Gram-negative bacillus, P. aeruginosa. The golden circular colony is a Gram-positive coccus in grape-like clusters, S.aureus. The semi-translucent colony with watery edges is a Grampositive coccus which may show chain formation and is therefore Ent. faecalis.